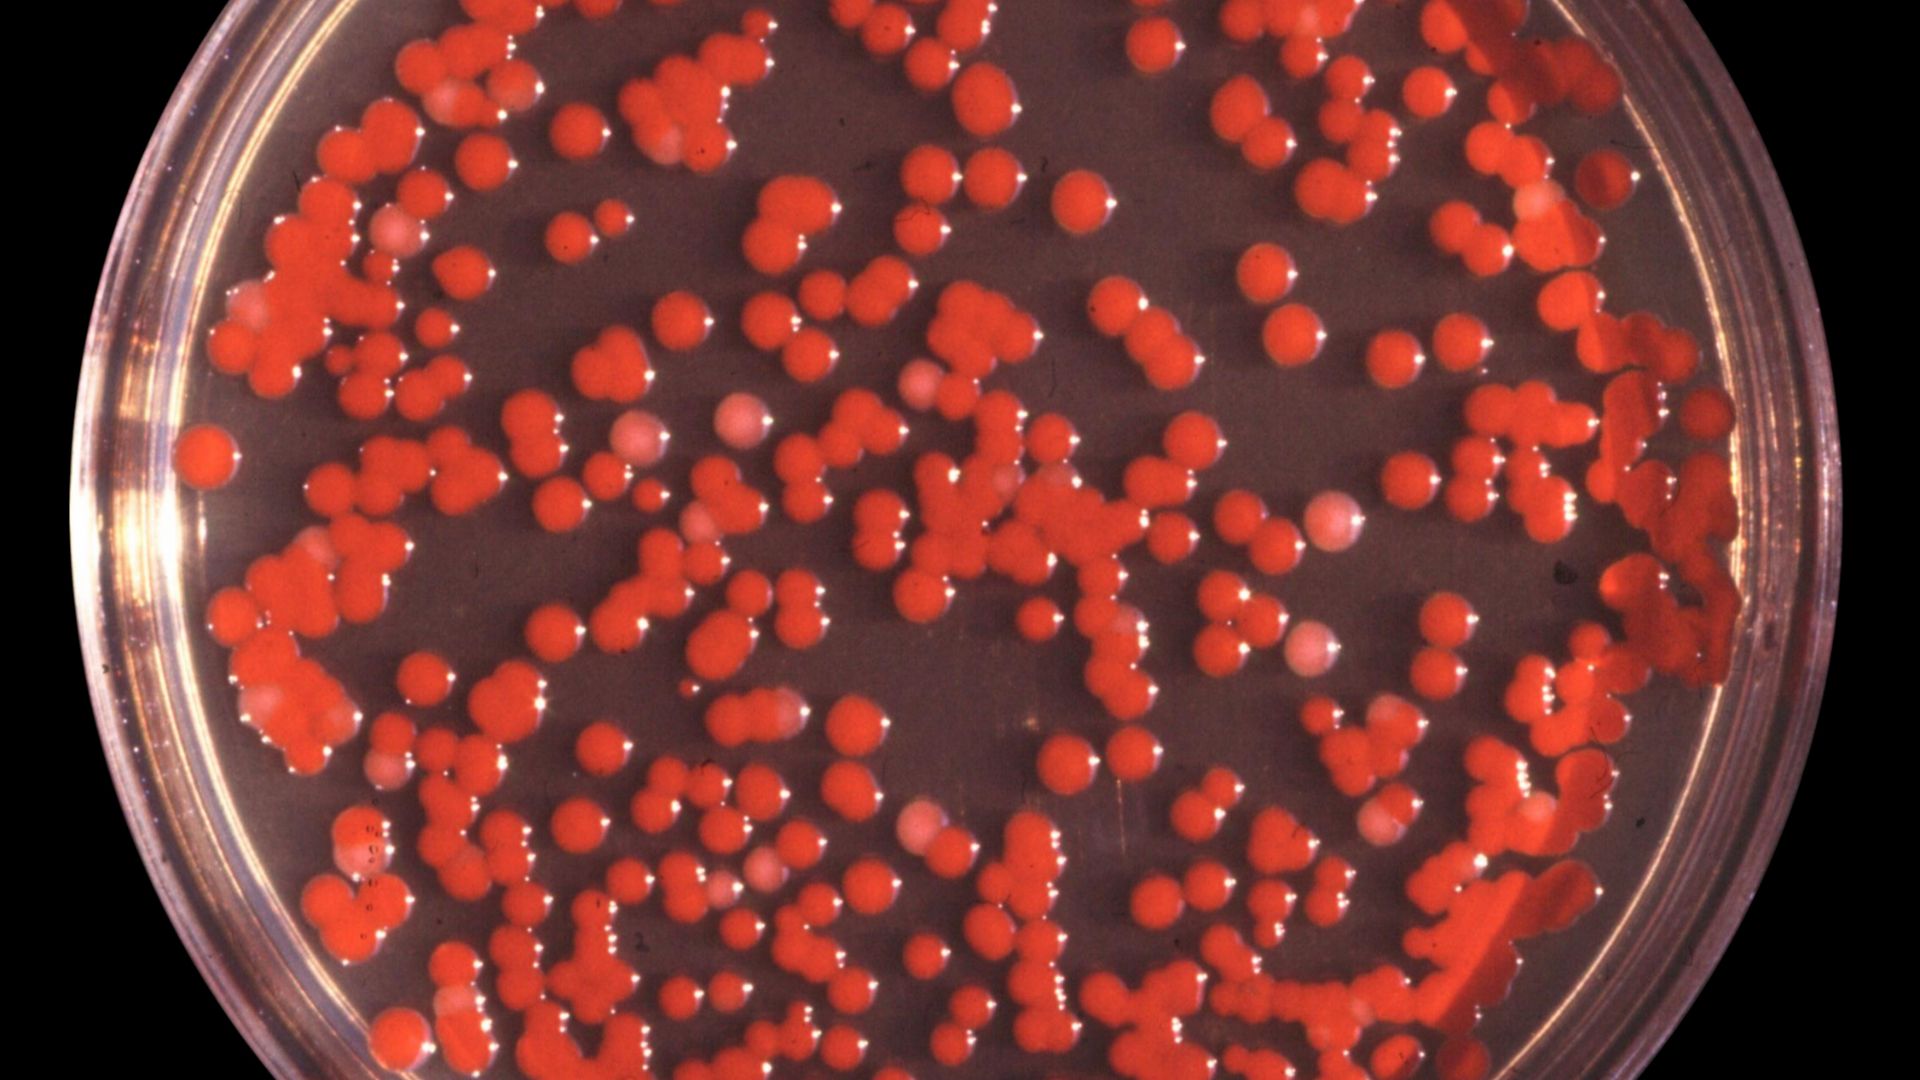
File:Serratia marcescens.jpg

Whispered Stories That Investigators Proved Were Real
Someone somewhere swore these stories were true. However, the majority laughed them off as tales of government mind experiments. Then archives opened, investigators dug deeper, and the folklore everyone dismissed turned into documented history.
 Wunabbis, CC BY-SA 4.0, Wikimedia Commons, Modified
Wunabbis, CC BY-SA 4.0, Wikimedia Commons, Modified
The Body Under The Hotel Mattress
Travelers complained about foul odors in budget motels, joking about what died in the walls. In 1999, police found a corpse decomposing beneath a mattress at the Burgundy Motor Inn after guests reported the smell. Similar discoveries occurred in Memphis, Kansas City, and Las Vegas.
 Markus Spiske markusspiske, Wikimedia Commons
Markus Spiske markusspiske, Wikimedia Commons
Funhouse Cadaver Was A Real Human (Elmer McCurdy)
Carnival attractions featured painted mannequins and rubber dummies that delighted crowds for decades. Television crew members filming The Six Million Dollar Man in 1976 moved what they assumed was a prop, only to discover Elmer McCurdy's mummified remains hanging in a California funhouse since 1916.
CIA Mind Control Experiments (MKUltra)
Conspiracy theorists long suspected government agents secretly drugged citizens to study mind control. Those fears gained credibility in 1975, when congressional hearings revealed Project MKUltra. Between 1953 and 1973, the CIA tested hallucinogens on thousands without consent, even observing drugged clients inside San Francisco brothels.
 Central Intelligence Agency, Wikimedia Commons
Central Intelligence Agency, Wikimedia Commons
Poisoned Halloween Candy (Ronald Clark O'Bryan Case)
Parents long warned children about poisoned treats from strangers, but that fear largely traces back to one real crime that happened in 1974. Here, Ronald Clark O’Bryan poisoned his own son’s Pixy Stix with cyanide to collect insurance money. He was executed in 1984.
Razor Blades Hidden In Halloween Apples
Concern over tampered Halloween candy came from rare, isolated incidents rather than a trend. Beginning in the 1960s, a few cases involved needles, pins, or laxatives, often pranks or acts by known individuals. Injuries were uncommon and usually minor. A confirmed 2000 Minneapolis case involved needles placed in candy bars, slightly injuring one child.
 CoffeeAddict, Wikimedia Commons
CoffeeAddict, Wikimedia Commons
Charlie No-Face, The Green Man Of Pittsburgh (Raymond Robinson)
Teenagers drove backroads at night seeking glimpses of a glowing green figure with a melted face. Raymond Robinson survived a childhood electrical accident in 1919 that destroyed his eyes, nose, and one arm. He walked Pennsylvania highways after dark for decades, becoming a local legend that drivers genuinely encountered until his death in 1985.
Today’s Prohibited Substances In Coca-Cola's Original Formula
Soda fountain patrons claimed the beverage contained addictive substances beyond sugar and caffeine. John Pemberton's original 1886 recipe included coca leaf extract containing approximately nine milligrams of this substance per glass. The company removed all traces of the alkaloid by 1903 after federal pressure.
 User:C`est moi-es, Wikimedia Commons
User:C`est moi-es, Wikimedia Commons
John Wayne Gacy Performed As Pogo The Clown While Murdering Victims
During the 1970s, John Wayne Gacy performed publicly as Pogo and Patches the Clown while secretly torturing and taking young men’s lives in his Norwood Park basement. When 1978 came, police uncovered 29 bodies beneath his Chicago home, cementing the clown image as a source of real fear.
 Martin Zielinski, Wikimedia Commons
Martin Zielinski, Wikimedia Commons

History's most fascinating stories and darkest secrets, delivered to your inbox daily.
Government Officials Kept Human Remains At The Smithsonian
Indigenous communities pushed for the return of ancestral remains held in museum collections for research. Congressional investigations revealed that the Smithsonian stored more than 8,000 Native American bodies and burial items obtained through grave robbing. These collections remained until the 1990 Native American Graves Protection and Repatriation Act mandated their return.
 User:Noclip, Wikimedia Commons
User:Noclip, Wikimedia Commons
MacArthur Causeway Face-Eating Attack Shocks Florida
In May 2012, a brutal public assault near Miami’s MacArthur Causeway shocked the nation. Rudy Eugene attacked a homeless man, Ronald Poppo, in broad daylight, and he caused severe facial injuries before police fatally shot him. Later toxicology reports found only marijuana in Eugene’s system.
 Mike Shaheen, Wikimedia Commons
Mike Shaheen, Wikimedia Commons
Doctors Left Surgical Instruments Inside Patients's Bodies
Medical malpractice lawsuits exposed cases where surgeons closed incisions without accounting for all tools. Hospital X-rays later revealed scalpels, sponges, clamps, and surgical towels left inside patients. These retained foreign objects occur in roughly one out of every five thousand surgeries, according to nationwide malpractice insurance databases.
Safety Coffins With Bells Were Installed For People Buried Alive
Victorian fears of premature burial inspired stories of coffins with escape devices. Patent records show dozens of safety coffin designs using bells, flags, and air tubes. Duke Ferdinand of Brunswick in 1792 demanded a burial vault with windows, ventilation, and a lock opening only from inside.
 Unknown authorUnknown author, Wikimedia Commons
Unknown authorUnknown author, Wikimedia Commons
Operation Sea-Spray: Government-Tested Biological Weapons On Citizens
San Francisco residents dismissed claims that the military tested biological warfare over the city. Those claims proved real when Navy ships released Serratia marcescens and Bacillus globigii across the Bay Area in September 1950. Edward Nevin later passed on from a Serratia infection, and his family’s lawsuit forced the experiment’s declassification decades later.
de:Benutzer:Brudersohn, Wikimedia Commons
de:Benutzer:Brudersohn, Wikimedia Commons
Tuskegee Syphilis Experiments On Black Men
Rural Alabama communities circulated rumors that doctors allowed Black men to go untreated. Those claims proved true when the US Public Health Service enrolled 600 sharecroppers near Tuskegee from 1932 to 1972, promised medical care, withheld penicillin, and documented untreated syphilis as participants succumbed to complications.
 National Archives Atlanta, GA (U.S. government), Wikimedia Commons
National Archives Atlanta, GA (U.S. government), Wikimedia Commons
Giant Rats Roam Major Cities
Urban dwellers swapped stories about rodents as large as house pets prowling subway tunnels and alleyways. New York sanitation workers regularly encounter rats weighing 1 to 2 pounds. London's super-rats, documented by pest control companies, exceed fifteen inches in length without tails, thriving on discarded fast food and resisting conventional poison treatments.
 Andrey Giljov, Wikimedia Commons
Andrey Giljov, Wikimedia Commons
Soviet Scientists Reanimated Dead Dogs In Experiments
Cold War–era footage showed Soviet scientists performing startling life-support experiments dismissed as staged. Physiologist Sergei Brukhonenko built the autojektor in the early 1920s, a heart-lung device. He demonstrated it worked by sustaining a severed dog’s head for over an hour in 1925, maintaining external circulation to stimuli.
 Russian Academy of Medical Sciences, Wikimedia Commons
Russian Academy of Medical Sciences, Wikimedia Commons
CIA Faked Vampire Attacks To End Philippine Rebellion
Filipino insurgents spread stories of killings where victims seemed drained of blood with puncture wounds. In the 1950s, Colonel Edward Lansdale staged psychological warfare by leaving exsanguinated bodies in Huk areas. Guerrillas abandoned positions after corpses were arranged to mimic aswang attacks by intelligence operatives.
 US Air Force, Wikimedia Commons
US Air Force, Wikimedia Commons
Bermuda Triangle Linked To Real Disappearances
Several losses around the Bermuda Triangle happened before the name existed. The USS Cyclops vanished with 300 crew members in 1918. Navy Flight 19 disappeared during a mission in 1945. Both tragedies entered legend despite explanations involving weather, navigation error, and routine maritime risk.
Andes Plane Crash Survivors Ate The Dead To Survive
Uruguayan Air Force Flight number 571 crashed in October 1972, and it stranded survivors at 11,000 feet without food for 72 days. Rescue teams later heard impossible accounts about rugby players resorting to cannibalism after the crash. Roberto Canessa confirmed the acts, turning taboo rumor into documented survival history.
Loch Ness Sightings Linked To Giant Eels
For generations, locals reported large moving shapes beneath Loch Ness’s dark surface. A 2019 environmental DNA study detected genetic material from unusually large eels living in the loch. Researchers suggested oversized eels could explain some sightings, offering a biological source for reported shapes without evidence of a distinct unknown creature.
Body Snatchers Stole Corpses For Medical School Anatomy Lessons
Graveyards hired guards after families reported fresh graves robbed at night. During the 1800s, medical schools paid resurrection men to supply bodies for anatomy classes. In 1828, Burke and Hare took out 16 people in Edinburgh, and they exposed a corpse trade serving medical schools across Britain and America.
 Kim Traynor, Wikimedia Commons
Kim Traynor, Wikimedia Commons
The Great Molasses Flood Was Real And Deadly
In January 1919, a storage tank burst in Boston’s North End, and it released over two million gallons of molasses. The fast-moving flood killed 21 people, injured more than 100, and left parts of the city sticky for decades. Bostonians had long repeated these stories.
The Dancing Plague Of 1518 Actually Happened
Medieval accounts described townspeople dancing uncontrollably until collapsing or dying, often dismissed as exaggeration. In reality, in July 1518, residents of Strasbourg began dancing nonstop for days or weeks. Contemporary records from doctors and city officials confirm that some passed on from exhaustion, strokes, and heart failure.
 Pieter Brueghel the Younger, Wikimedia Commons
Pieter Brueghel the Younger, Wikimedia Commons
Dyatlov Pass Incident Was Not A Hoax
Back in 1959, nine experienced hikers passed on under mysterious conditions near Dyatlov Pass. Declassified files, forensic evidence, and a 2020 Russian investigation concluded a rare slab avalanche caused panic, injuries, and hypothermia, confirming the tragedy while dispelling supernatural explanations.
 AnonymousUnknown author / Soviet investigators, Wikimedia Commons
AnonymousUnknown author / Soviet investigators, Wikimedia Commons
Tunguska Explosion Flattened A Forest Without A Crater
Stories spread of a massive blast in Siberia that knocked people off their feet hundreds of miles away. On June 30, 1908, an explosion flattened over 800 square miles of forest near the Tunguska River. Later expeditions confirmed a midair asteroid or comet detonation event.
 Leonid Kulik, the expedition to the Tunguska event, Wikimedia Commons
Leonid Kulik, the expedition to the Tunguska event, Wikimedia Commons



















